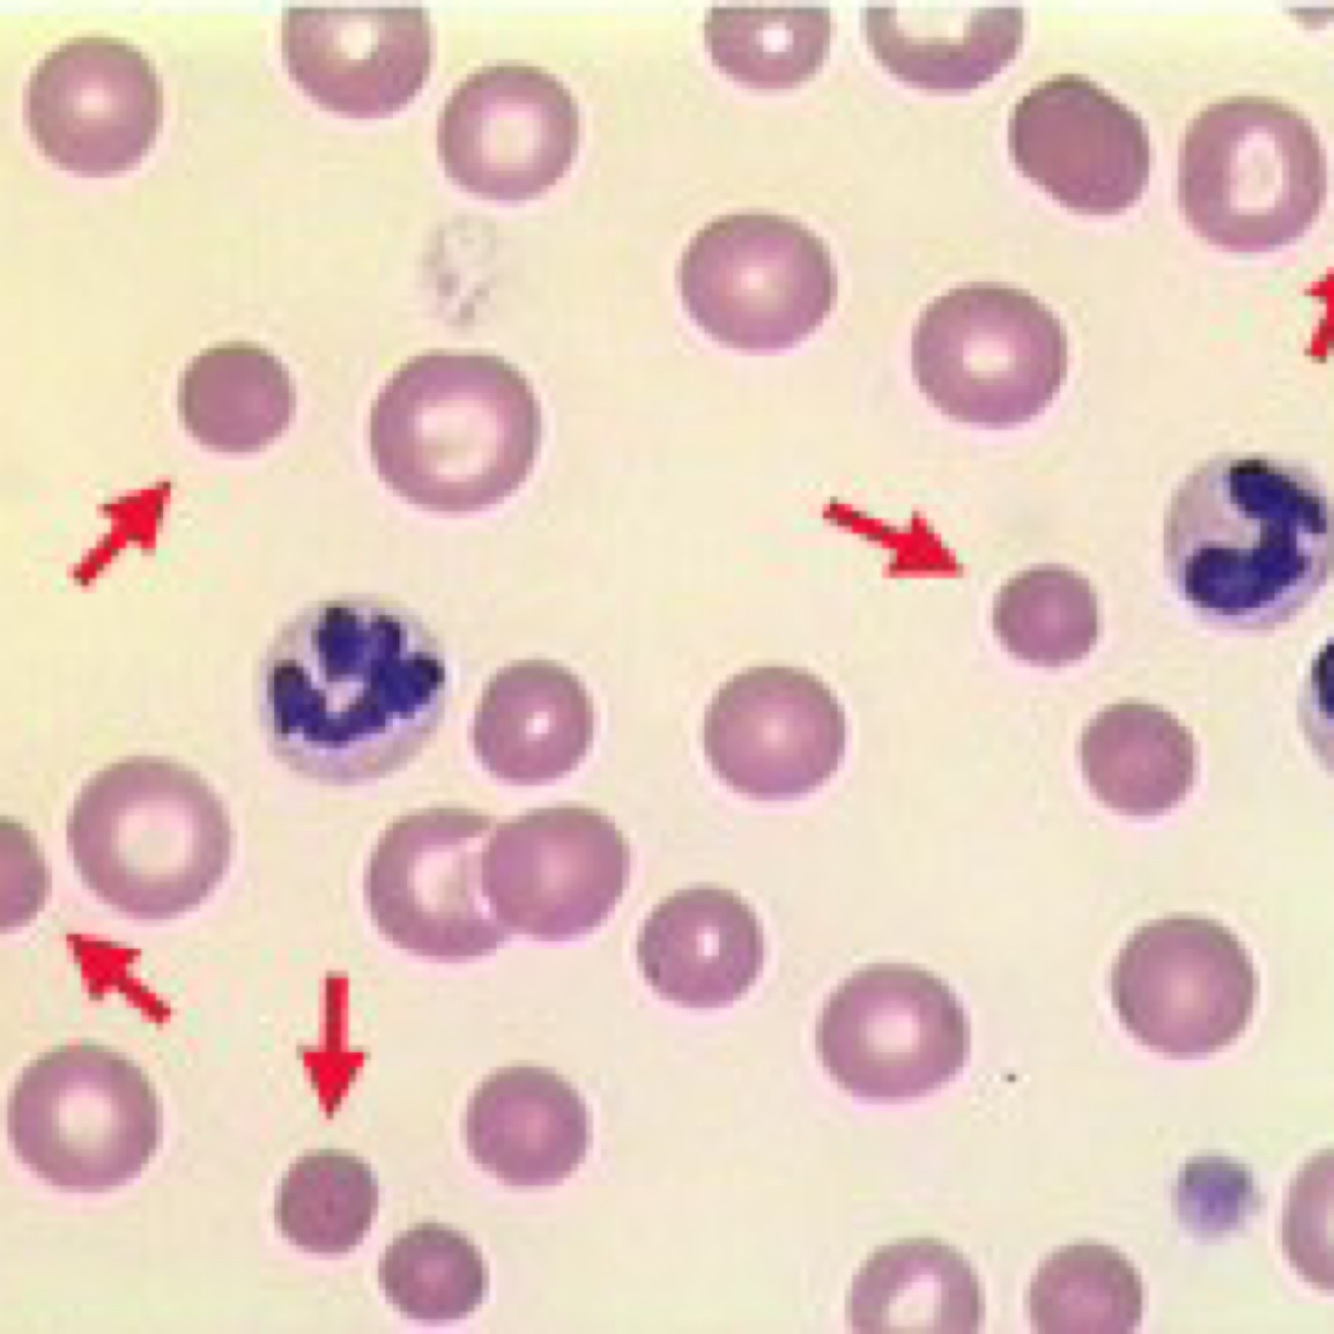

Platelet counts are usually < ______ in ITP
10,000
Anemia if present should be Regenerative or NR?
Regenerative
Can take several days for regeneration to be evident after acute bleed
Rest of BW is usually unremarkable in 1º ITP. T/F
T
Clotting times are abnormal in ITP. T/F
False
they are NORMAL
PT,PTT are increased in ITP. T/F
False
Clotting times are normal
If you suspect ITP but the platelet count is >30,000, then what do you expect as differentials? - - - -
- Rat poison
- Rickettsial disease
- Cancer
- 2º to sepsis
Main DD for ITP?
- Rat poison
- Cancer
- Evans syndrome
- Severe DIC
In Evans syndrome, you expect concurrent IMHA with _____ & other evidence of hemolysis
SPHEROCYTES
What do you discern from a Cavalier King Charles Spaniel with platelet count at 30,000
They have Macro-thrombocytopenia
Platelets can be as low as 30,000 and be normal
No juglar sticks and no cystos in cases of ITP. T/F
T
Diagnostics in cases of ITP?
-CBC(with pathologist review)/Chem/ UA +/- UC
-Clotting panel
-Tick PCR or 4DX if low risk
+/- SAT if anemic to r/o evan’s syndrome
+/- CXR,AUS
+/- BM if not typical ITP
When to consider BM sampling?
If not typical ITP
Which test to do to r/o Evan’s Syndrome if ITP suspected pet is anemic?
Saline Agglutination Test
SAT
Why consider CXR,AUS?
To r/o underlying cancer
Especially important if older
Rx for Evan’s Syndrome ?
-Corticosteroids
-Doxycyline
-Gastroprotectants +/- anti-emetics
-Blood tranfusion products
+/- vincristine and aminocaproic acid
Regarding corticosteroids as Rx for ITP?
Initially, Dexamethasone 0.2 mg/kg IV once if not eating or vomiting and then Prednisone 1 mg/kg PO BID
Regarding Doxycycline as Rx for ITP?
5 mg/kg PO BID pending tick PCR or 14 d if tick PCR not done
Which gastroprotectants to use?
Omeprazole + Sucralfate
Separate carafate from other drugs by atleast 1 hr
Which blood tranfusion product to choose?
- if active bleeding → FRESH whole blood (Fresh blood preferred over stored)
- if not currently bleeding but anemia → pRBC
When to consider Vincristine in cases of ITP?
- use once
- if not vomiting and WBC is normal
- Wear gloves while using
- 02 mg/kg IV
* *use IV catheter <24 hr old
What other medications to consider if pet not responding?
Aza-thio-prine
Myco-phenolate
Cyclosporine


